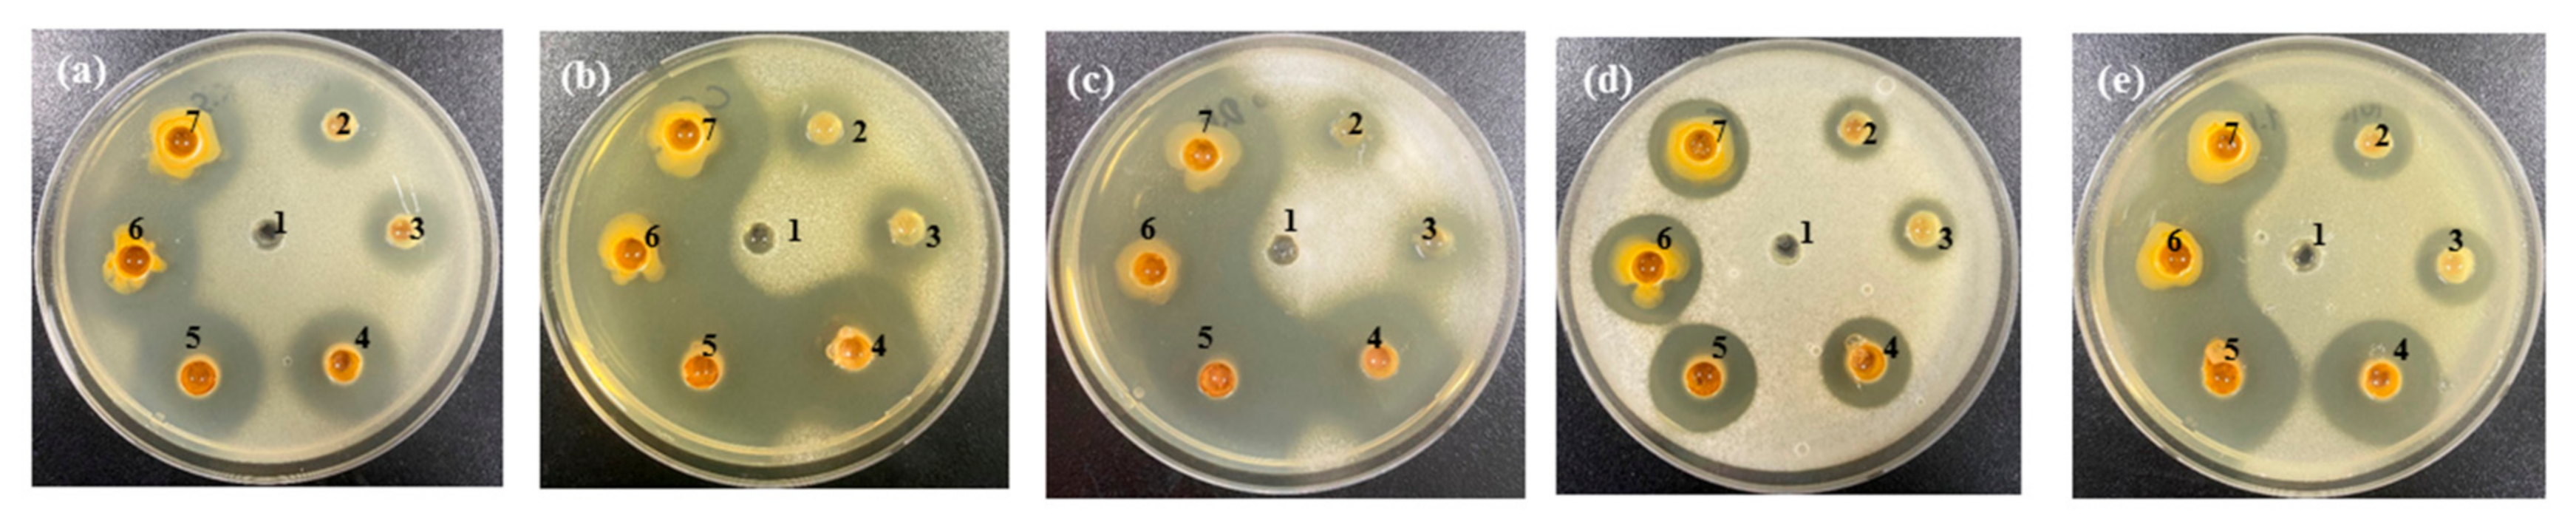
Foods 10 00645 g005 Foods 10 00645 g005
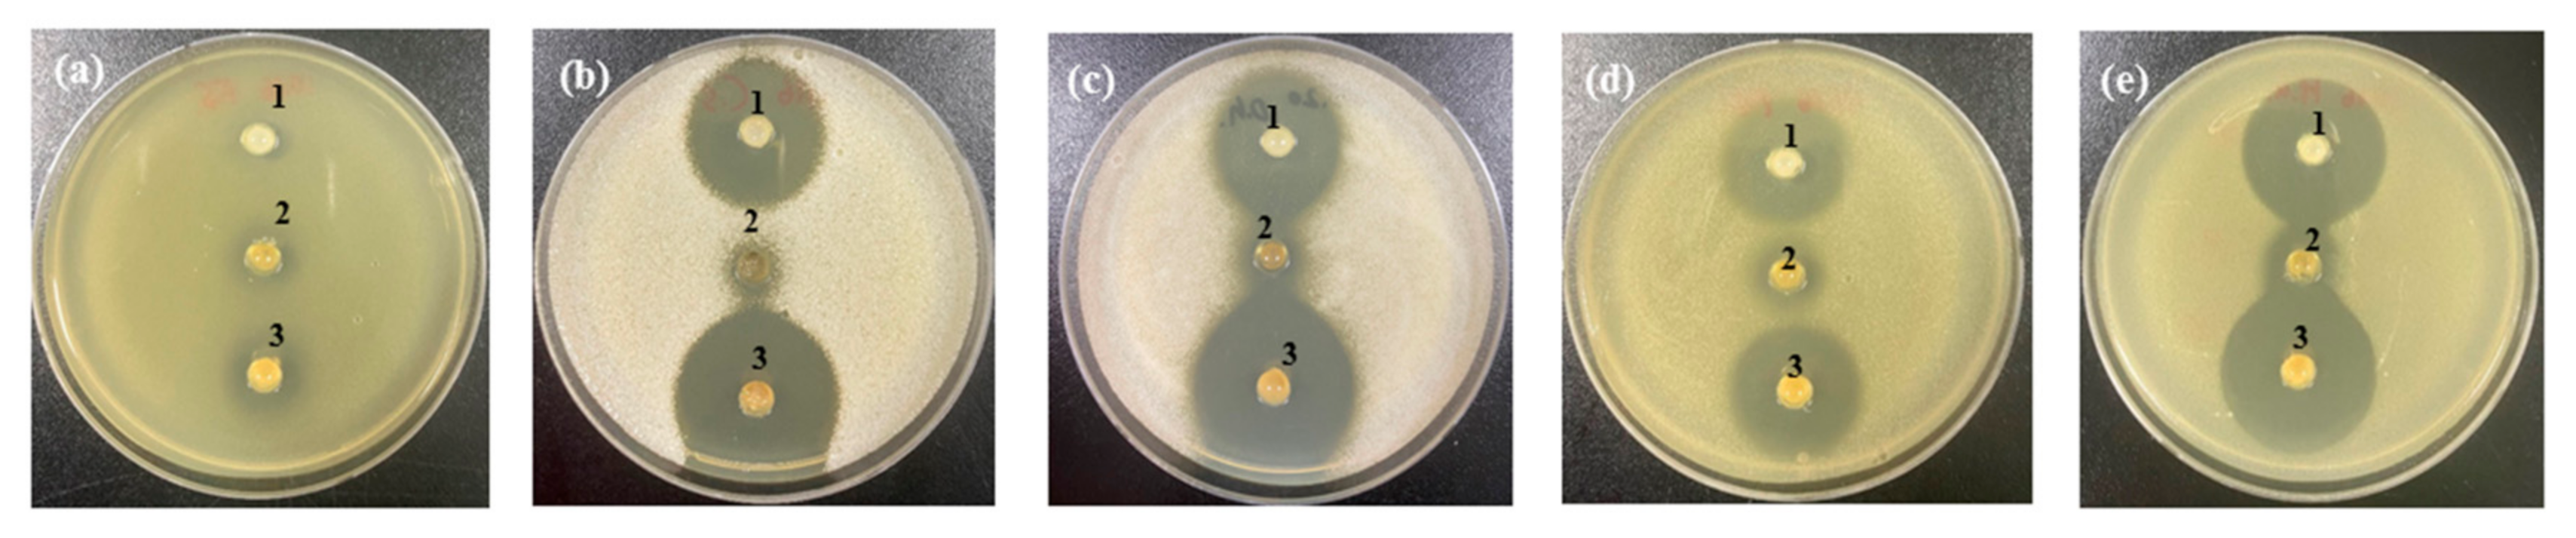
Foods 10 00645 g006 Foods 10 00645 g006

Growth Inhibitory Effect of Garlic Powder and Cinnamon Extract on White Colony-Forming Yeast in Kimchi
Abstract
1. Introduction
2. Materials and Methods
2.1. Yeast Strains
2.2. Growth of WCFY under Different Conditions
2.3. Preparation of FGP and CEE
2.4. Analysis of Alliin and Cinnamaldehyde Content
2.5. Anti Yeast Activity of FGP, CEE, and the FGP and CEE Mixture
2.6. Sensory Analysis
2.7. Application of the FGP and CEE Mixture in Kimchi
2.8. Statistical Analysis
3. Results
3.1. Growth Ability of WCFY under Different Cultivation Conditions
3.1.1. Temperature
3.1.2. pH
3.1.3. Salinity
3.1.4. Anaerobic Conditions
3.2. Anti Yeast Activity of Garlic and Cinnamon against WCFY
3.3. Anti Yeast Activity of the FGP and CEE Mixture against WCFY
3.4. Application of the FGP and CEE Mixture on Kimchi
3.4.1. Application of the FGP and CEE Mixture on Kimchi Inoculated WCFY
3.4.2. Application of the FGP, CEE, and Xanthan Gum on Kimchi
4. Conclusions
Author Contributions
Funding
Institutional Review Board Statement
Informed Consent Statement
Data Availability Statement
Conflicts of Interest
References
- Lee, S.H.; Jung, J.Y.; Jeon, C.O. Source tracking and succession of kimchi lactic acid bacteria during fermentation. J. Food Sci. 2015, 80, M1871–M1877. [Google Scholar] [CrossRef]
- Jung, J.Y.; Lee, S.H.; Jeon, C.O. Kimchi microflora: History, current status, and perspectives for industrial kimchi production. Appl. Microbial. Biotechnol. 2014, 98, 2385–2393. [Google Scholar] [CrossRef]
- Moon, S.H.; Chang, M.; Kim, H.Y.; Chang, H.C. Pichia kudriavzevii is the major yeast involved in film-formation, off-odor production, and texture-softening in over-ripened Kimchi. Food Sci. Biotechnol. 2014, 23, 489–497. [Google Scholar] [CrossRef]
- Suzuki, A.; Muraoka, N.; Nakamura, M.; Yanagisawa, Y.; Amachi, S. Identification of undesirable white-colony-forming yeasts appeared on the surface of Japanese kimchi. Biosci. Biotechnol. Biochem. 2018, 82, 334–342. [Google Scholar] [CrossRef] [PubMed]
- Kim, J.Y.; Kim, J.; Cha, I.T.; Jung, M.Y.; Song, H.S.; Kim, Y.B.; Lee, C.; Kang, S.Y.; Bae, J.W.; Choi, Y.E.; et al. Community structures and genomic features of undesirable white colony-forming yeasts on fermented vegetables. J. Microbiol. 2019, 57, 30–37. [Google Scholar] [CrossRef]
- Kim, M.J.; Lee, H.W.; Kim, J.Y.; Kang, S.E.; Roh, S.W.; Hong, S.W.; Yoo, S.R.; Kim, T.W. Impact of fermentation conditions on the diversity of white colony-forming yeast and analysis of metabolite changes by white colony-forming yeast in kimchi. Food Res. Int. 2020, 136, 109315. [Google Scholar] [CrossRef] [PubMed]
- Martorell, P.; Stratford, M.; Steels, H.; Fernández-Espinar, M.T.; Querol, A. Physiological characterization of spoilage strains of Zygosaccharomyces bailii and Zygosaccharomyces rouxii isolated from high sugar environments. Int. J. Food Microbial. 2007, 114, 234–242. [Google Scholar] [CrossRef] [PubMed]
- Pérez-Díaz, I.M.; McFeeters, R.F. Preservation of acidified cucumbers with a natural preservative combination of fumaric acid and allyl isothiocyanate that target lactic acid bacteria and yeasts. J. Food Sci. 2010, 75, M204–M208. [Google Scholar] [CrossRef]
- Shwaiki, L.N.; Arendt, E.K.; Lynch, K.M.; Thery, T.L. Inhibitory effect of four novel synthetic peptides on food spoilage yeasts. Int. J. Food Microbiol. 2019, 300, 43–52. [Google Scholar] [CrossRef] [PubMed]
- Pérez-Díaz, I.M. Preservation of acidified cucumbers with a combination of fumaric acid and cinnamaldehyde that target lactic acid bacteria and yeasts. J. Food Sci. 2011, 76, M473–M477. [Google Scholar] [CrossRef]
- Yang, E.J.; Seo, Y.S. Stability of anti-yeast activities and inhibitory effects of defatted green tea seed extracts on yeast film formation. J. Korean Soc. Food Sci. Nutr. 2017, 46, 327–334. [Google Scholar] [CrossRef]
- Xu, W.; Qu, W.; Huang, K.; Guo, F.; Yang, J.; Zhao, H.; Luo, Y. Antibacterial effect of grapefruit seed extract on food-borne pathogens and its application in the preservation of minimally processed vegetables. Postharvest Biol. Technol. 2007, 45, 126–133. [Google Scholar] [CrossRef]
- Kim, Y.S.; Kyung, K.H.; Kim, Y.S. Inhibition of soy sauce film yeasts by allyl isothiocyanate and horse-radish powder. Korean J. Food Nutr. 2000, 13, 263–268. [Google Scholar]
- Kim, H.J.; Semeneh, S.; Ammara, A.; Kim, B.J.; Park, J.G.; Kang, S.N. Antioxidant and antimicrobial activity in oat (Avena sativa L.) leaf extracts and its effect on the characteristics of emulsion sausage. J. Agri. Life Sci. 2020, 54, 83–92. [Google Scholar] [CrossRef]
- Hu, F.; Tu, X.F.; Thakur, K.; Hu, F.; Li, X.L.; Zhang, Y.S.; Zhang, J.G.; Wei, Z.J. Comparison of antifungal activity of essential oils from different plants against three fungi. Food Chem. Toxicol. 2019, 134, 110821. [Google Scholar] [CrossRef]
- Choi, Y.J.; Jin, H.Y.; Yang, H.S.; Lee, S.C.; Huh, C.K. Quality and storage characteristics of yogurt containing Lacobacillus sakei ALI033 and cinnamon ethanol extract. J. Anim. Sci. Technol. 2016, 58, 16. [Google Scholar] [CrossRef]
- Sallam, K.I.; Ishioroshi, M.; Samejima, K. Antioxidant and antimicrobial effects of garlic in chicken sausage. LWT-Food Sci. Technol. 2004, 37, 849–855. [Google Scholar] [CrossRef]
- Nazari, M.; Ghanbarzadeh, B.; Kafil, H.S.; Zeinali, M.; Hamishehkar, H. Garlic essential oil nanophytosomes as a natural food preservative: Its application in yogurt as food model. Colloid Interface Sci. Commun. 2019, 30, 100176. [Google Scholar] [CrossRef]
- Leontiev, R.; Hohaus, N.; Jacob, C.; Gruhlke, M.C.; Slusarenko, A.J. A comparison of the antibacterial and antifungal activities of thiosulfinate analogues of allicin. Sci. Rep. 2018, 8, 1–19. [Google Scholar] [CrossRef]
- Balaguer, M.P.; Lopez-Carballo, G.; Catala, R.; Gavara, R.; Hernandez-Munoz, P. Antifungal properties of gliadin films incorporating cinnamaldehyde and application in active food packaging of bread and cheese spread foodstuffs. Int. J. Food Microbiol. 2013, 166, 369–377. [Google Scholar] [CrossRef]
- Kurtzman, C.P.; Robnett, C.J. Identification and phylogeny of ascomycetous yeasts from analysis of nuclear large subunit (26S) ribosomal DNA partial sequences. Antonie van Leeuwenhoek 1988, 73, 331–371. [Google Scholar] [CrossRef]
- Zhu, Q.; Kakino, K.; Nogami, C.; Ohnuki, K.; Shimizu, K. An LC-MS/MS-SRM method for simultaneous quantification of four representative organosulfur compounds in garlic products. Food Anal. Methods 2016, 9, 3378–3384. [Google Scholar] [CrossRef]
- Helal, A.; Tagliazucchi, D.; Verzelloni, E.; Conte, A. Bioaccessibility of polyphenols and cinnamaldehyde in cinnamon beverages subjected to in vitro gastro-pancreatic digestion. J. Funct. Foods 2014, 7, 506–516. [Google Scholar] [CrossRef]
- Cizeikiene, D.; Juodeikiene, G.; Paskevicius, A.; Bartkiene, E. Antimicrobial activity of lactic acid bacteria against pathogenic and spoilage microorganism isolated from food and their control in wheat bread. Food Control 2013, 31, 539–545. [Google Scholar] [CrossRef]
- Zhang, T.; Jeong, C.H.; Cheng, W.N.; Bae, H.; Seo, H.G.; Petriello, M.C.; Han, S.G. Moringa extract enhances the fermentative, textural, and bioactive properties of yogurt. LWT-Food Sci. Technol. 2019, 101, 276–284. [Google Scholar] [CrossRef]
- Choi, Y.M.; Whang, J.H.; Kim, J.M.; Suh, H.J. The effect of oyster shell powder on the extension of the shelf-life of kimchi. Food Control 2006, 17, 695–699. [Google Scholar] [CrossRef]
- Park, S.J.; Park, K.Y.; Jun, H.K. Effects of commercial salts on the growth of kimchi-related microorganisms. J. Korean Soc. Food Sci. Nutr. 2001, 30, 806–813. [Google Scholar]
- Meng, X.; Lee, K.; Kang, T.Y.; Ko, S. An irreversible ripeness indicator to monitor the CO2 concentration in the headspace of packaged kimchi during storage. Food Sci. Biotechnol. 2015, 24, 91–97. [Google Scholar] [CrossRef]
- Lee, J.S.; Jeong, S.; Lee, H.G.; Cho, C.H.; Yoo, S. Development of a sulfite-based oxygen scavenger and its application in Kimchi packaging to prevent oxygen-mediated deterioration of Kimchi quality. J. Food Sci. 2018, 83, 3009–3018. [Google Scholar] [CrossRef]
- Jang, H.J.; Lee, H.J.; Yoon, D.K.; Ji, D.S.; Kim, J.H.; Lee, C.H. Antioxidant and antimicrobial activities of fresh garlic and aged garlic by-products extracted with different solvents. Food Sci. Biotechnol. 2018, 27, 219–225. [Google Scholar] [CrossRef] [PubMed]
- Oh, T.Y.; Kyung, K.H. Isolation and purification of garlic specific organic compounds. Korean J. Food Sci. Technol. 2011, 43, 553–557. [Google Scholar] [CrossRef]
- Lawson, L.D.; Wang, Z.J. Low allicin release from garlic supplements: A major problem due to the sensitivities of alliinase activity. J. Agri. Food Chem. 2001, 49, 2592–2599. [Google Scholar] [CrossRef]
- Marchese, A.; Barbieri, R.; Sanches-Silva, A.; Daglia, M.; Nabavi, S.F.; Jafari, N.J.; Lzadi, M.; Ajami, M.; Nabavi, S.M. Antifungal and antibacterial activities of allicin: A review. Trends Food Sci. Technol. 2016, 52, 49–56. [Google Scholar] [CrossRef]
- Kim, J.Y.; Lee, Y.C.; Kim, K.S. Effect of heat treatments on the antimicrobial activities of garlic (Allium sativum). J. Microbiol. Biotechnol. 2002, 12, 331–335. [Google Scholar]
- Chae, S.K. Studies on the changes in the alliinase activity during the drying of garlic. Korean J. Sanitation. 2007, 22, 57–66. [Google Scholar]
- Abdel-Mallek, A.Y.; Bagy, M.M.K.; Hasan, H.A.H. The in vitro anti-yeast activity of some essential oils. J. Islam. Acad. Sci. 1994, 7, 10–12. [Google Scholar]
- Shreaz, S.; Sheikh, R.A.; Bhatia, R.; Neelofar, K.; Imran, S.; Hashmi, A.A.; Manzoor, N.; Basir, S.F.; Khan, L.A. Antifungal activity of α-methyl trans cinnamaldehyde, its ligand and metal complexes: Promising growth and ergosterol inhibitors. Biometals 2011, 24, 923–933. [Google Scholar] [CrossRef]
- Makwana, S.; Choudhary, R.; Dogra, N.; Kohli, P.; Haddock, J. Nanoencapsulation and immobilization of cinnamaldehyde for developing antimicrobial food packaging material. LWT-Food Sci. Technol. 2014, 57, 470–476. [Google Scholar] [CrossRef]
- Kim, N.M.; Yang, J.W.; Kim, W.J. Effect of ethanol concentration on index components and physicochemical characteristics of cinnamon extracts. Korean J. Food Sci. Technol. 1993, 25, 282–287. [Google Scholar]
- Wen, P.; Zhu, D.H.; Wu, H.; Zong, M.H.; Jing, Y.R.; Han, S.Y. Encapsulation of cinnamon essential oil in electrospun nanofibrous film for active food packaging. Food Control. 2016, 59, 366–376. [Google Scholar] [CrossRef]
- Khumkomgool, A.; Saneluksana, T.; Harnkarnsujarit, N. Active meat packaging from thermoplastic cassava starch containing sappan and cinnamon herbal extracts via LLDPE blown-film extrusion. Food Packag. Shelf Life 2020, 26, 100557. [Google Scholar] [CrossRef]
- D’amore, T.; Stewart, G.G. Ethanol tolerance of yeast. Enzyme Microb. Technol. 1987, 9, 322–330. [Google Scholar] [CrossRef]
- Alexandre, H.; Rousseaux, I.; Charpentier, C. Ethanol adaptation mechanisms in Saccharomyces cerevisiae. Biotechnol. Appl. Biochem. 1994, 20, 173–183. [Google Scholar]
- You, K.M.; Rosenfield, C.L.; Knipple, D.C. Ethanol tolerance in the yeast Saccharomyces cerevisiae is dependent on cellular oleic acid content. Appl. Environ. Microbiol. 2003, 69, 1499–1503. [Google Scholar] [CrossRef] [PubMed]

| Sample | Alliin (mg/L) |
|---|---|
| 10% FGP | 32.73 ± 4.99 c |
| 20% FGP | 63.41 ± 9.16 b |
| 30% FGP | 93.38 ± 14.58 a |
| Raw garlic filtrate | 60.43 ± 0.55 bc |
| Cinnamon Extract | Cinnamaldehyde (mg/L) |
|---|---|
| Extracted by water | 581.79 |
| Extracted by hot water | 89.22 |
| Extracted by 30% ethanol | 2942.29 |
| Extracted by 50% ethanol | 9278.27 |
| Extracted by 80% ethanol | 11,521.08 |
| Extracted by 100% ethanol | 7832.66 |
| Parameter | Control | 10% FGP + 1.75% CEE | 10% FGP + 2% CEE |
|---|---|---|---|
| Appearance | 5.50 ± 1.28 a | 4.27 ± 1.55 a | 4.64 ± 1.51 a |
| Smell | 4.70 ± 1.79 a | 4.40 ± 1.69 a | 3.80 ± 0.87 a |
| Taste | 6.00 ± 1.26 a | 5.20 ± 1.25 ab | 4.40 ± 1.20 b |
Publisher’s Note: MDPI stays neutral with regard to jurisdictional claims in published maps and institutional affiliations. |
© 2021 by the authors. Licensee MDPI, Basel, Switzerland. This article is an open access article distributed under the terms and conditions of the Creative Commons Attribution (CC BY) license (http://creativecommons.org/licenses/by/4.0/).
Share and Cite
Kim, M.-J.; Kang, S.-E.; Jeong, C.H.; Min, S.-G.; Hong, S.W.; Roh, S.W.; Jhon, D.-Y.; Kim, T.-W. Growth Inhibitory Effect of Garlic Powder and Cinnamon Extract on White Colony-Forming Yeast in Kimchi. Foods 2021, 10, 645. https://doi.org/10.3390/foods10030645
Kim M-J, Kang S-E, Jeong CH, Min S-G, Hong SW, Roh SW, Jhon D-Y, Kim T-W. Growth Inhibitory Effect of Garlic Powder and Cinnamon Extract on White Colony-Forming Yeast in Kimchi. Foods. 2021; 10(3):645. https://doi.org/10.3390/foods10030645
Chicago/Turabian StyleKim, Mi-Ju, Seong-Eun Kang, Chang Hee Jeong, Sung-Gi Min, Sung Wook Hong, Seong Woon Roh, Deok-Young Jhon, and Tae-Woon Kim. 2021. "Growth Inhibitory Effect of Garlic Powder and Cinnamon Extract on White Colony-Forming Yeast in Kimchi" Foods 10, no. 3: 645. https://doi.org/10.3390/foods10030645
APA StyleKim, M.-J., Kang, S.-E., Jeong, C. H., Min, S.-G., Hong, S. W., Roh, S. W., Jhon, D.-Y., & Kim, T.-W. (2021). Growth Inhibitory Effect of Garlic Powder and Cinnamon Extract on White Colony-Forming Yeast in Kimchi. Foods, 10(3), 645. https://doi.org/10.3390/foods10030645

